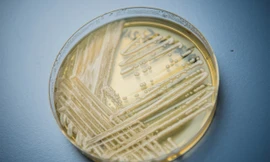
Hình ảnh nấm Candida.

Australia phát hiện siêu khuẩn kháng thuốc đầu tiên
TPO - Ngày 7/8, giới chức y tế Australia cảnh báo, một bang của Australia đã phát hiện trường hợp nhiễm siêu vi kháng thuốc đầu tiên đối với một bệnh nhân nhiều khả năng đã nhiễm khuẩn từ một loài nấm kháng thuốc tại Anh.